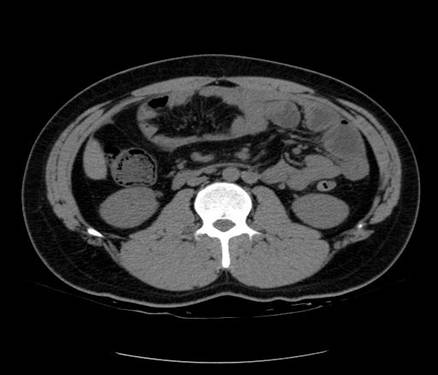

以下是引用zsl6918在2007-6-22 21:08:00的发言:[br]病史较长,反复发作,基本排除恶性病变,腹部定位像可见是小肠梗阻征象,原因无非是肠源性,血管性和神经性的,肠源性的在排除占位后应想到 肠旋转不良的可能,血管性的应想到肠系膜血管的栓塞,神经性的要想到植物神经功能紊乱的可能,本病例应该强化检查帮助诊断,个人感觉旋转不良可能性大。
以下是引用青莲居士在2007-6-24 12:27:00的发言:[br]肠梗阻[br]肝内胆管结石
| 欢迎光临 医影在线 (http://bbs.radida.com/bbs/) | Powered by Discuz! X3.2 |